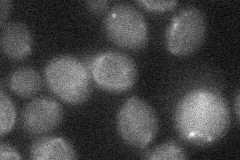

View description
JmjC domain-containing histone demethylase; transcription factor involved in the expression of genes during nutrient limitation; also involved in the negative regulation of DPP1 and PHR1
Localization:
Intensity:
Fold change:
Significance:
-
C’ GFP library in SD

nucleus28.5 -
N' NOP1pr-GFP in SD

punctate39.2218 -
N' TEF2pr-mCherry in SD

punctate38.6552 -
N' NATIVEpr-GFP in SD

punctate32.9427 -
N' TEF2pr-VC and Cyto-VN in SD
below threshold22.8336 -
C’ GFP library in SD+DTT

technical problem0N/ANo -
C’ GFP library in SD+H2O2

nucleus29.691.04No -
C’ GFP library in Starvation Media

nucleus32.171.12No -
C’ GFP library on the background of Pup2-DaMP

nucleus -
C’ GFP library on the background of CCT mutant

nucleus26.44550.927887No
